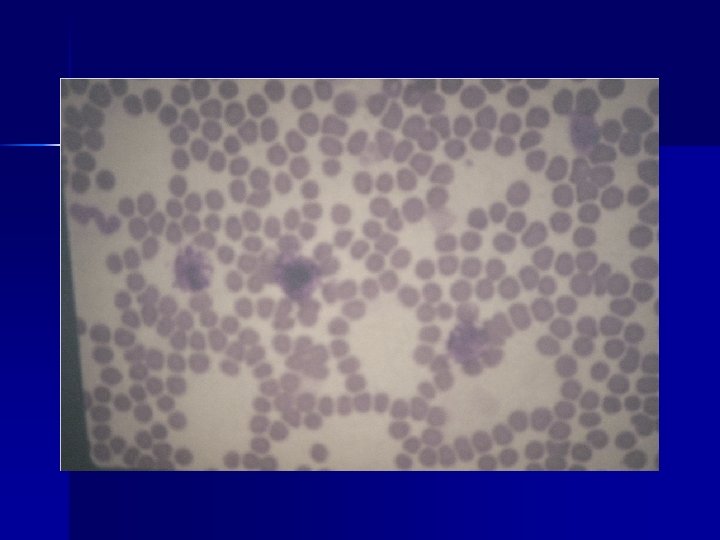

German Shorthaired Pointer National Specialty Show2013 What Happens

- Slides: 103
German Shorthaired Pointer National Specialty Show-2013 What Happens to Your GSP with a Diagnosis of Cancer? K. Ann Jeglum, V. M. D. , ACVIM, Oncology
Oncology: Diagnostics and Therapies in Today’s Times K. Ann Jeglum, V. M. D. Diplomate, ACVIM, Oncology Adjunct Associate Professor The Wistar Institute, Philadelphia Veterinary Oncology Services and Research Center Veterinary Oncology Services’ Radiation Center
Diagnostics in Today’s Times n n n Important to obtain a definitive diagnosis as practically as possible Costly diagnosis leaves no funds to treat Clinical staging based on needs to prognosticate for owners – Ex. Abdominal ultrasound in lymphoma does not change prognosis nor protocol unless GI signs – Ex. Role of abdominal US in mast cell tumors – Ex. Role of thoracic US vs. radiographs
Advanced Imaging: MRI and CT Scans n n Significant role in staging for treatment of head and neck tumors, ie, nasal, oral, brain Pulmonary tumors: CT Recognize potential of costly treatment, ie, radiation, after imaging Critical for diagnosis and treatment planning of brain tumors- surgical biopsies rare – Prognosis based on anatomic site and MRI appearance
Role of Ultrasound as Medical Oncologist n n Diagnosis and staging of intraabdominal disease with US-guided needle aspirate Evaluation and cytology of thoracic masses Treatment follow-up of bladder, prostate, liver, adrenal, GI tumors- course of treatment based on results Surgical planning extemitiy, soft tissue and thyroid masses
Definition of “Effective” Treatment in Today’s Times n n Quality of life not quantity- palliative vs. therapeutic treatment Cost effectiveness “Reasonable” prognosis based on owner expectations and outcome Treating the disease and not the clienttherapeutic doses vs. subtherapeutic causing more harm than good – Ex. Low dose, infrequent chemotherapy enhances MDR- q 3 week chemo in lymphoma not treating the disease
Cancer Therapy in Today’s Times n Chemotherapy – Nucleus: kills by breaking DNA n Molecular Targeted Therapy – Cytoplasma: inhibits signal transduction allowing programmed cell death or apoptossis n Anti-Angiogenesis Therapy – Tumor microenvironment: inhibits growth factors that promote tumor vasculature
Canine Mammary Tumors Higher incidence in purebreed- breeding n Overall 50: 50% Benign to Malignant n Of the 50% malignant half are surgically cured n Therefore 25% overall life threatening n Size does not predict malignancy n Early detection and early resection n Surgical Approach: Radical vs. Simple mastectomy- en bloc lymph node resectionl n
Soft Tissue Sarcomas n n n Histopathology: fibrosarcoma, spindle cell sarcoma, histiocytic sarcoma, peripheral nerve sheath, hemangiopericytoma Surgery initial treatment of choice Local control: radiation therapy Anaplastic pathology: doxorubicin/DTIC Histiocytic sarcoma/malignant histiocytosisbreed related prognosis Young dogs <5 yrs. - very aggressiveneoadjuvant chemotherapy
Malignant Histiocytosis/ Histiocytic Sarcoma n n n Genetic predisposition: Bernese Mountain dogs, Flat-coated Retrievers, Golden Retrievers (reported VOSRC, 2008) Increasing incidence Differentiate systemic disease (MH) from localized Sites of Involvement: soft tissue, spleen, liver, lymph nodes, lung, bone marrow Classification/Nomenclature changes- P. Moore (UCDavis)
Histiocytic Diseases Histiocytes: subset of leukocytes including monocytes, macrophage, dendritic antigen presenting cells (DAPCs) n Cutaneous Histiocytoma n – Benign, proliferation of CD 1+, CD 11 c+, Thy-1, CD 4 - Langerhans cells
Histiocytic Diseases n Reactive Histiocytosis – Cutaneous and systemic forms – Angiocentric, CD 11 c+, Thy 1+, CD 4 + DAPCs – Considered an immunoregulatory disorder and repsonds to immunosuppressive therapy
Histiocytic Sarcoma Localized and dissminated n Large round cells with spindiloid cells with increased cytoplasmic: nuclear ratio- diagnosed on cytology or histo n Immuophenotype of DAPCs n Clinically aggressive with high rate of metastases n Systemic therapy generally indicated n
Therapy of Histiocytic Sarcoma n Chemotherapy – VOSRC gold standard: Doxorubicin/DTIC n Bone marrow involvement- poor prognosis – CCNU +/- cyclophosphamide n ECOG trial- dismal results
Alternative Therapies for Histiocytic Sarcoma n n Radiation therapy for local and/or regional disease- 19 daily @ 3 Gy fractions to 57 Gy TALL-104 Cell Line Therapy – Wistar Intitute – Effective but not available- internet question n Biphosphanates- Pamidronate – Based on responsed in human Langerhan’s cell histiocytosis – B. Kitchell- responses in individual cases
Management of Mast Cell Tumors K. Ann Jeglum, V. M. D. The Wistar Institute Philadelphia, Pennsylvania West Chester, Pennsylvania
Radiation Therapy and Chemosensitization n n Hypoxic cells are resistant to radiation Low dose of chemotherapy drugs will sensitize hypoxic cells in bulky tumors to radiation kill Several drugs inhibit DNA repair or sublethal radiation damage Drugs used: cisplatin, carboplatin, dactinomycin d, doxorubicin, gemcitabine
Canine Osteosarcoma n n n A cancer of large and giant breeds Median age of 10 years but an aggressive subset in young (18 -24 mos) Occur at metaphysis of rapidly growing bones- predispositionalso trauma sites, ie, fractures, internal fixation devicesdifferent biological behavior 75% in long bones, ie, “away from the elbow and around the knee” and hock Radiographic appearance: lytic, osteoblastic and mixedcortical lysis, periosteal reaction (“sunburst”) Differential Diagnoses: fungal disease, infection, other primary bone tumors (fibrosarcoma, chondrosarcoma, hemangiosarcoma), hemopoietic tumors (LSA, myeloma)
Canine Osteosarcoma. Diagnosis n n n “Pathognomonic” diagnosis of history, clinical signs, anatomic site and radiographic appearance Dilemmas with biopsy- non-diagnostic with reactive bone using an invasive procedure that may result in vascular release, increase pain and lameness and increase risk for pathologic fracture Characteristic appearance of other bone tumors Geographic predisposition for mycotic diseases Not indicated if amputation is definitive treatment
Canine Osteosarcoma. Staging and Prognosis Thoracic Radiographs: negative in >90% cases at initial diagnosis Evidence of micrometastases at time of diagnosisdisputed by anticoagulation data during amputation Favorable Prognostic Factors: low serum alkaline phophatase, intracompartmental lesions, small primary tumor, parosteal osteosarcomas, axial and mandibular sites, tumor necrosis following chemotherapy- role of neoadjuvant chemo?
Canine Osteosarcoma: Where Are We? n No significant change in survival or disease free interval in the 15+ years since advent of platnum compounds Amputation + 4 cycles of cisplatin=median survivals=260 -400 days with 1 year survival of 3062%- not all disease free at 1 yr. – 2 year survival rates 6 -21% n n n Doxorubicin alone < 1 yr. median survival Surgical limb salvage procedures Amputation vs. palliative radiation followed by chemotherapy
Canine Osteosarcomacon’t. n Protocol changes to improve prognosis: – Combine cisplatin and doxorubicin in alternating cycles – Increase number of cycles to 6 – Introduce additonal chemotherapeutic agents such as ifosfamide – No new cytotoxic agents- high dose methotrexate problematic in dogs – Maintenance metronomic chemotherapy – No effective treatment for metastatic disease
Canine Osteosarcomacon’t. Current VOSRC protocol post amuputation or palliative radiation n Cisplatin (60 mg/M 2) alternating with Doxorubicin (30 mg/M 2 every 3 weeks 3 cycles each n Historically cisplatin first- recently doxorubicin before platum compound may be more effective n
Canine Osteosarcoma. Palliative Radiation and Biphosphonates n n Weekly radiation therapy to primary tumor (9 Gy weekly X 4=36 Gy) Biphosphonate- Pamidronate 1 mg/kg intravenous infusion over min. 2 hours every 3 weeks Increase calcification of tumor, decrease bone pain and now antitumor effects Controversy of value of chemotherapy in such a model
Biphosphonate Therapy in Bone Tumors n n Osteosarcoma and metastatic malignant tumors induce and stimulate osteoclasts to invade bone Can be osteolytic or osteoblastic and osteoclasts has important role in both patterns Tumors produce many factors that stimulate osteolysis, osteosclerosis and aggressive tumor growth Osteoclastic targeted therapies: biphophonatesinduction osteoclast apoptosis
Metronomic Chemotherapy n n n Chronic administration of chemotherapy at low, minimally toxic doses on a frequent schedule of administration at close regular intervals, with no prolonged drug-free breaks Could less be more? Origins in pediatric oncology- similarities to vet onco Antiangiogenic by targeting endothelial cellsmore sensitive to continuous exposure of chemotherapy drugs without undergoing genetic mutations like tumor cells that develop drug resistance
Metronomic Chemotherapy- con’t. n n Major mechanism is inhibition of mobilization of endothelial cells that develop in bone marrow and seeds tissue Bone marrow-derived endothelial cells are major source on new blood vessels to tumor cells Also stimulates production of thrombospondin-1, a potent angiogenesis endogenous inhibitor Low dose cyclophosphamide also depletes regulatory T-cells which are immunosuppressive on effector T-cells and antigen presenting cells
Metronomic Chemotherapy + COX-2 Inhibitors n n Cyclooxygenase-2 is over expressed in tumors cells and stromal cells and promotes tumor growth by stimulation angiogenesis Overexpression of COX-2 stimulates growth factors (VEFG) COX also plays role in generation of T-reg cells Synergism of two approaches- metronomics plus COX-2 inhibitors
Metronomic Protocol Piroxicam 0. 3 mg/kg po sid- Cox-2 inhibitor as antiangiogenic n Chlorambucil 0. 1 mg/kg po EOD or Cyclophosphamide 10 -15 mg/M 2 EOD but hemorhagic cystitis a problem n Doxycycline 5 mg/kg bid n Methotrexate 0. 05 -0. 1 mg/kg once weekly- no piroxicam n
Metronomic Chemotherapy + COX-2 Inhibitors n n Piroxicam only NSAID in dogs with proven in vitro and in vivo antitumor activity Low-dose cyclophosphamide plus piroxicam – Increased DFI in dogs with completely resected splenic hemangiosarcoma compared to doxorubicin alone- small nos. (Lana, JVIM, 2007) – Delay tumor recurrences in soft tissues recurrences in incompletely excised soft tissue sarcomas (peripheral nerve sheath) (Elmslie, JVIM, 2008)- retrospective
Canine Hemangiosarcoma Tumor of vascular endothelium n Prevalent sites: spleen, liver, right atrium, lung, subcutaneous, bone n Clinical presentations include abdominal bleed, pericardial effusioncardiac tamponade n Proven inherited in GRs! (Jeglum) GSHPs? n Not a death sentence n
Canine Hemangiosarcoma n n n Soft tissue vs. splenic HSA- different diseases- long term survival with chemotherapy of soft tissue Do we change biological behavior of splenic with adjuvant chemotherapy? Doxorubicin/dacarbazine- objective tumor responses in measurable metastatic disease- not seen with doxo alone or with addition of cyclophosphamide However, after 4 cycles A/DTIC still develop metastases but not during- delay of mets? Improvement? More chemotherapy vs. maintenance metronomics
Doxorubicin (Adriamycin) and Dacarbazine (DTIC) Day 1 : Doxorubicin 30 mg/M 2 slow IV n Days 1 -5 DTIC 200/mg 2 IV bolus n Days 4 -5 Complete Blood Count (CBC) n Day 10 CBC n Day 21 Start 2 nd cycle X 4 cycles n Prophylactic antiemetics (Cernia, Centrine, Zofran) and antibiotics n
Oral Tumors n Diagnostics – Cytology vs. surgical biopsy – Staging: lymph node aspirate, thoracic radiographs – MRI for treatment planning: surgical resection, radiation therapy
Oral Tumors- con’t. n Squamous Cell Carcinoma – Treatment based on anatomic site and size of tumor – Rostral: segmental mandibulectomy or maxillectomy – Caudal: neoadjuvant chemotherapy vs. radiation therapy +/- chemosensitization – Role of systemic chemotherapy with local therapy dependent on histopathology – Cats: BAC- doxorubicin, cyclophophamide, bleomycin – Dogs: Cisplatin, 5 -FU
Oral Tumor- con’t n Sarcomas – Changes in histopathology: spindle cell sarcoma, fibrosarcoma – Surgical approach similar to SCC – Radiation therapy +/- chemosensitization with dactinomycin – Systemic chemotherapy: dactinomycin, doxorubicin/dtic – Application dependent on pathology/cytology
Tyrosinase- Melanoma Antigen Tyrosinase- a protein present on normal canine cutaneous melanocytes and overexpressed on melanoma cells n Not normally targeted by the immune system- CMV trains the immune system to recognize tumor-associated protein or antigen n
Canine Melanoma n n n Two malignant sites: oral cavity (gingiva, palate, tongue) and subungal (digit) Locally invasive and metastatic to regional lymph nodes and distant sites, primarily lung also liver, kidney and brain Dermal melanomas historically considered benign but recently increase in malignant cutaneous melanoma- can be multicentric
Xenogeneic Plasmid DNA Vaccine Technology n n n A non-canine (human) tyrosinase is inserted in a ring of canine DNA= xenogeneic plasmid DNA containing canine DNA for human tyrosinase Foreign tyrosinase breaks through the dog’s tolerance of a self tumor thereby inducing a strong and active immunity Results in production of human antigen that is homologous to canine tyrosinase but recognized as foreign
Xenogeneic Plasmid DNA Vaccine Technology- con’t The antigen is transcribed in the host and actively presented by the immune system during malignant transformation targeting melanoma cells as foreign n The immune response appears tumorspecific targeting tumor producing cells not normal melanocytes n
Canine Melanoma Vaccine - ONCEPT n Historically dogs with WHO stage II or III oral melanoma treated with surgery alone have survival times <5 -6 mos. – WHO Stage II: approximately 150 -180 days – WHO Stage III: approximately 60 -90 days
Canine Melanoma Vaccine - ONCEPT- con’t n n n Local disease control achieved through surgery (negative local lymph nodes or positive lymph nodes that were surgically removed or irradiated 58 dogs with stage II or III COM treated by vaccination with ONCEPT following local disease control Follow-up survival data 6 mos. after conclusion of the study, <50% have died of melanoma (median survival time not attained)
Canine Melanoma Vaccine -ONCEPT n n Quantile estimates of survival time for vaccinates (25% mortality {95% confidence intervals was 464 days Significant difference between historical stagematched controls and vaccinates with better survival times with vaccinates (p<0. 0001) No significant association in response between stage II and III (p=0. 58) No difference in survival in dogs with post-surgical histological clean surgical boarders vs. narrow or dirty margins
Canine Melanoma Vaccine - ONCEPT Phil Bergman: 20% response in gross disease n Radiation and vaccine- administer in conjunction to achieve immune response to ag release at tumor death n VOSRC experience: local and regional control essential n
Canine Malignant Melanoma n Advanced stage disease – Cisplatin/dacarbazine – Vs. Carboplatin- 15 -20% loss of efficacy with chemotherapy analogues
Genitourinary Tract Tumors n n n Increased incidence of prostate tumors especially prostate in neutered males Chemotherapy of Prostate: Mitoxantrone Transitional Cell Carcinoma: – – – Diagnosis with ultrasound and urine cytology Piroxicam alone: 20 -25% ORR Chemotherapy: doxorubicin/cyclophophamide, mitoxantrone, gemcitabine
Anal Sac Carcinomas n n n Surgery based on size and invasiveness of local tumor Regional lymph node metastases common on US staging “Barrier” effect of lymph node- prolonged survival without distant metastases Role of chemotherapy to prevent clinical signs Protocols: FAC- doxorubicin, 5 -FU, cyclophosphamide alternating with carboplatin
Palladia (toceranib phosphate) n FDA approved for the “treatment of grade II or III, recurrent, cutaneous mast cell tumors with or without regional lymph node involvement in dog
Palladia- con’t. n “Mult-center, Placebo-controlled, Double-blind, Randomized Study of Oral Toceranib Phosphate (SU 11654), a Receptor Tyrosine Kinase Inhibitor, for the Treatment of Dogs with Recurrent (Either Local or Distant) Mast Cell Tumor Following Surgical Exicision” London CA, Clin Cancer Res 2009: 15(11)3856 -3865.
Palladia-con’t. n n Blinded Phase: 6 weeks- 3. 25 mg/kg EODthereafter, eligible dogs received open-label Palladia Blinded phase ORR in Palladia-treated dogs (n=86)=37. 2% (7 CR and 25 PR) vs. 7. 9% (5 PR) in placebo-treated (n=63; p=0. 0004) Of 58 dogs that received Palladia following placebo-escape, 41. 4% (8 CR, 16 PR) had ORR in 145 dogs receiving Palladia was 42. 8% (21 CR, 41 PR)
Palladia- con’t. n n n 62 Responders: Median duration of objective response= 12 weeks and median time to progression= 18. 1 weeks Survival time was not an end point and not reported Dogs with positive c-kit ITD were more likely to have an objective response compared to those negative (44. 8% vs. 20. 3%)
Palladia- con’t. n Most common adverse events- majority grade 1 or 2 – – – – Diarrhea 46% Vomiting 32. 2% Blood in stool 12. 6% Anorexia 39. 1% Neutropenia 46% Weight loss 14. 9% Musculoskeletal 25%
Palladia- con’t. Grade 3 or 4 adverse were 20. 7% in Pallladia treated vs. 15. 6% of placebo (p=0. 527) n Toxicities secondary to mast cell disease and degranulation n
Canine Lymphoma n n n VCAA: L-asparaginase, vincristine, cyclophosphamide, doxorubicin- single agent, weekly for 4 weeks X 2 cycles UW (Kirk’s CT) Protocol Standard of Care but long term maintenance not necessarydecreased to 12 wk. without significant differences Quality of life, cost effectiveness and avoidance of multi-drug resistance
Canine Lymphoma-cont. n n n Importance of bone marrow aspirate as 1520% involvement without hematological changes Mechanism of early relapse Referral disease or not? “Tricks of the trade”- when to cross over to rescue protocols Combined treatment to determine MDR Importance of doxorubicin/DTIC
Veterinary Oncology Services and Research Center West Chester, PA n n n K. Ann Jeglum, V. M. D. , Diplomate, ACVIM, Oncology Donna L. Lindner, D. V. M. , Board eligible surgery, 9 years medical oncology Vicky Nelson, D. V. M. , Board eligible internal medicine, 8 years medical oncology Lisa Suslack-Brown, V. M. D. , Diplomate, ACVR Kenneth Sadanaga, D. V. M. Diplomate, ACVS Michael Miller, V. M. D. , cardiology
Veterinary Oncology Services’ Radiation Center Chalfont, PA n n n Drs. Jeglum, Lindner, Nelson Dr. Patrick Gavin, Diplomate, ACVROradiation planning Sue Chipollini, Board Certified Radiation Therapist- 25 yrs. Experience Tracey Murphy, Board Certified Radiation Therapist- 20 yrs. Experience Linear accelerator 6 Mv with photons and electrons and simulator Full capacity medical oncology facility
Canine Mast Cell Tumor: Clinician’s Dilemma Heterogeneous Biological Behavior Prognostic Factors in Management of Mast Cell Tumors 1. Is this a first time occurrence of the MCT of is it recurrent? Is the tumor in the same site or different site? Recurrent disease requires adjuvant therapy following re-excision 2. What is the anatomical site of the tumor? Is it solitary or multicentric? Anatomic sites with a more malignant behavior despite histological grade include: Genitalia (male) and inguinal(? )/ perineal area Mammary gland in female Oral cavity Digit or dorsum of paw
Canine Mast Cell Tumors: Heterogeneous Biological Behavior (cont. ) 3. What is the growth rate? Slow growing and indolent (benign), slow growing with a rapid growth spurt (becoming malignant), rapid growth and invasion from onset (malignant). 4. What does the biopsy report tell about the grade of malignancy of the mast cells? Despite which numerical system may be used, a description of the cells is critical. Are the surgical boarders devoid of tumor cells?
Biology of Mast Cells Normal cells of connective tissue- most numerous underlying serosal surfaces, mucous membranes and dermis Most Common site of tumor formation is skin and subcutaneous Spleen, liver, GI, oral cavity Characteristically have metochromatic granules containing vasoactive substances including histamine, heparin.
Prognostic Factors in Canine Mast Cell Tumors Grade- I, III 1. • 2. 3. 4. Well-differentiated anaplastic Solitary vs. multicentric tumors Completeness of tumor excision Tumor site
Prognostic Factors in Canine Mast Cell Tumors (con’t) 5. Regional and distant metastasis, i. e. lymph node, liver, spleen (methods of evaluation? ) VCS Study: >100 cases buffy coats, ultrasound liver and spleen, bone marrows yielded <2% positive results 6. Recurrence in stage II tumors has negative impact on survival time
Prognostic Factors in Canine Mast Cell Tumors- con’t. 6. Mitotic Index: <5> MI/ 10 HPFMedian Survival Time (MST) Grade II: <5 MST=70 mos. >5 MST= 5 mos. (p<. 001) Grade III: <5= no MST attained >5 MST =<2 mos. (p<. 001) Vet Path 2007: 44(3)33541
Prognostic Factors in Canine Mast Cell Tumors- con’t. n 7. Cellular Proliferative Indices- results from the number of cycling cells (growth fraction) and rate of cell cycle progression (generation time) – Increased Ki 67 (growth fraction) and Ag. NOR (generation time) counts predict significantly recurrence at original site, distant metastases, MCT-related mortality rates, decreased survival times – Vet Path 2007: 44(3): 298 -308
Prognostic Factors in Canine Mast Cell Tumors- con’t. n 8. c-kit Mutations – c-kit proto-oncogene encodes the receptor tyrosine kinase KIT- important in normal mast cell survival, proliferation, differentiation, migration and cell death – Mutations result in increased cellular proliferation, higher histological grade, decreased disease-free and overall survival times
Medical Work-Up for Mast Cell Tumors 1. 2. 3. 4. 5. 6. Complete Blood Count +/- Buffy Coat Biochemical Profile Thoracic and Abdominal Radiographs Needle Aspirate of Regional Lymph Node Abdominal Ultrasound? Bone Marrow?
WHO Clinical Staging System for Mast Cell Tumors Stage I: One tumor confined to the dermis without regional lymph node involvement. a) b) Without systemic signs With systemic signs Stage II: One tumor confined to the dermis with regional lymph node involvement. a) b) Without systemic signs With systemic signs
WHO Clinical Staging System for Mast Cell Tumors (con’t) Stage III: Multiple dermal tumors; large infiltrating tumors with or without regional lymph node involvement. a) b) Without systemic signs With systemic signs Stage IV: Any tumor with distant metastasis or recurrence with metastasis.
Histologic Classification of Mast Cell Tumor
Survival Times of Dogs Based on Histologic Grade
Adjuvant Treatment of Canine Mast Cell Tumors Clinical Indications 1. Recurrent and/or multiplicity of tumors 2. Dirty surgical boarders 3. Malignant anatomic site, i. e. , inguinal area/ genitalia of male dog, mammary gland, digit or oral cavity. 4. Histological Grading - dependent on numerical classification used (Misdorp vs. Patnaik) Most important is the description of the morphology of the tumor cells ( well differentiated vs. anaplastic granular vs. agranular). 5. Lymph node metastases 6. Increased mitotic index
Management of Mast Cell Tumors 1. 2. 3. Surgical Excision- Cut Early, Wide and Deep Radiation Therapy- An extension of the Scapel for Local and Regional Disease Corticosteriods- Use Early in High Risk Disease Palliative in Advanced Disease Level I Protocol: Prednisone or Prednisolone 40 mg/m 2/day for 3 weeks, then 20 mg/m 2/day for 3 weeks and wean off Recommend H 2 and H 1 Antagonists
Management of Mast Cell Tumor (Cont. ) 4. Chemotherapy- Heterogeneous Response a) b) c) Level II: Chlorambucil 0. 2 mg/kg po sid X 6 mos +/Prednisone Level III: Vinblastine 2 mg/M 2 IV bolus weekly to response Level IV: Lomustine 70 mg/M 2 po q 3 - 4 wks 5. Immunotherapy- Observation Supporting Application a) Evidence of immunological defect- decreased antibody production- Howard, 1967 b) Adminstration of BCG resulting in fever and regression of MCTs- Jeglum, 1977 c) rh. TNF + rh. IL-2: Partial to complete necrosis in 6/6 dogs- Moore, et. Al, 1991
Molecular Targeted Therapeutics n Signal Transduction Targets – Intracytoplasmic – Mutations of genes resulting in uncontrolled growth – Assays for presence of such mutations – C-kit mutation in canine mast cell tumors – Therapeutic: Gleevac- iminatinib
Palladia (toceranib phosphate) n FDA approved for the “treatment of grade II or III, recurrent, cutaneous mast cell tumors with or without regional lymph node involvement in dog
Palladia- con’t. n “Mult-center, Placebo-controlled, Double-blind, Randomized Study of Oral Toceranib Phosphate (SU 11654), a Receptor Tyrosine Kinase Inhibitor, for the Treatment of Dogs with Recurrent (Either Local or Distant) Mast Cell Tumor Following Surgical Exicision” London CA, Clin Cancer Res 2009: 15(11)3856 -3865.
Palladia- con’t. 62 Responders: Median duration of objective response= 12 weeks and median time to progression= 18. 1 weeks n Survival time was not an end point and not reported n Dogs with positive c-kit ITD were more likely to have an objective response compared to those negative (44. 8% vs. 20. 3%) n
Palladia-con’t. n n Blinded Phase: 6 weeks- 3. 25 mg/kg EODthereafter, eligible dogs received open-label Palladia Blinded phase ORR in Palladia-treated dogs (n=86)=37. 2% (7 CR and 25 PR) vs. 7. 9% (5 PR) in placebo-treated (n=63; p=0. 0004) Of 58 dogs that received Palladia following placebo-escape, 41. 4% (8 CR, 16 PR) had ORR in 145 dogs receiving Palladia was 42. 8% (21 CR, 41 PR)
Palladia- con’t. n Most common adverse eventsmajority grade 1 or 2 – Diarrhea 46% – Vomiting 32. 2% – Blood in stool 12. 6% – Anorexia 39. 1% – Neutropenia 46% – Weight loss 14. 9% – Musculoskeletal 25%
Palladia- con’t DO NOT USE THE CLINICAL INSERT DOSING CHART (same for Pfizer’s Cerenia) n Current Recommendation per C. London n – Start dosing at 2. 75 mg/kg every other day – Use prophylactic antiemetics (Centrine, Cerenia – Dose escalate to 3. 25 mg/kg EOD based on toxicity profile
Masitinib- Inhibitor of KIT, A Receptor Tyrosinase Kinas Licensed by AB Science in Europe for veterinary use in November 2008 n Phase III Study- multicenter, randomized, placebo-controlled with measurable grade II or III mast cell tumors without regional or distant metastases- 202 dogs n 6 month treatment at dose of 1 2. 5 mg/kg/day n
Masitinib Phase III- con’t. Prolonged time to tumor progression (TTP) compared with placebo (75 to 118 days; p=. 038) n Effect more pronounced with first-line therapy – increase TTP from 75 to 253 days (p=. 001) regardless of expression of mutant vs. wild type KIT n Overall response assessed at 4 and 6 mos. not significantly increase by masitinib n
Masitinib Phase III- con’t. n n No significant differences with masitinib vs. placebo in proportion with CR (11. 2 vs 4. 9%) or PR (4. 6 vs 9. 8%) Toxicity – Significantly more diarrhea and vomiting with masitinib- 96. 2 % grade I or II- tolerable and transient and without sequelea – Neutropenia 6. 2% – Renal 7. 5% J Vet Intern Med 2008; 22: 1301 -1309
Clinical Consequences of Degranulation of Mast Cells 1. 2. Vomiting and/or Diarrhea- Not related to GI ulcer Gastrodoudenal Ulcers- Mechanisms: a) Histamine stimulates H 2 receptors resulting in excessive acid secretion and hypermotility b) Histamine causes vacular dilation that increases endothelial permeability leading to intravascular thrombosis and ischemic necrosis c) Clinical Signs: asymptomatic to anorexia, vomiting/ diarrhea +/- blood, anemia d) Perforated Ulcer- peritonitis, death
Clinical Management of Gastrointestinal Signs 1. H 2 blockers a) Cimetidine (Tagamet): 2 -4/mg/kg PO QID b) Ranitidine (Zantec): Dog: 2 mg/kg TID IV, PO c) Famotidine (Pepcid): 1 mg/kg SID, PO 2. Coating Agent: Sucralfate: 250 mg/15 kg PO QID Give 2 hours apart from other meds 3. Diphenhydramine (Benadryl): 2 -4 mg/kg q 6 -8 h PO, IM. If used IV, give very slowly due to hypotension.
Canine MCT Treatments
Controversies in the Management of Canine Mast Cell Tumors Heterogenous disease ≠Homogeous treatment Cohort studies vs. Individual cases 1. 2. • 3. 4. Mean DFI & Survival vs. Median Lack of controlled, prospective studies, compare treatment methods Extent of medical work-up: cytology, buffy coat, ultrasound
Controversies in the Management of Canine Mast Cell Tumors (con’t) To treat or not treat solitary grade II tumors Multicentric vs. metastatic disease Significance of prognostic factors Defining end points 5. 6. 7. 8. • • Ex: definition of reccurence, local at site vs. new MCT at distant site Time to tumor progression (Masitinib) vs response rate (Palladia)
Adjuvant Treatment of Canine Mast Cell Tumors Clinical Indications 1. Recurrent and/or multiplicity of tumors 2. Dirty surgical boarders 3. Malignant anatomic site, i. e. , inguinal area/ genitalia of dog, mammary gland, digit or oral cavity. male 4. Histological Grading - dependent on numerical classification used (Misdorp vs. Patnaik) Most important is the description of the morphology of the tumor cells ( well differentiated vs. anaplastic - granular vs. agranular). 5. Lymph node metastases